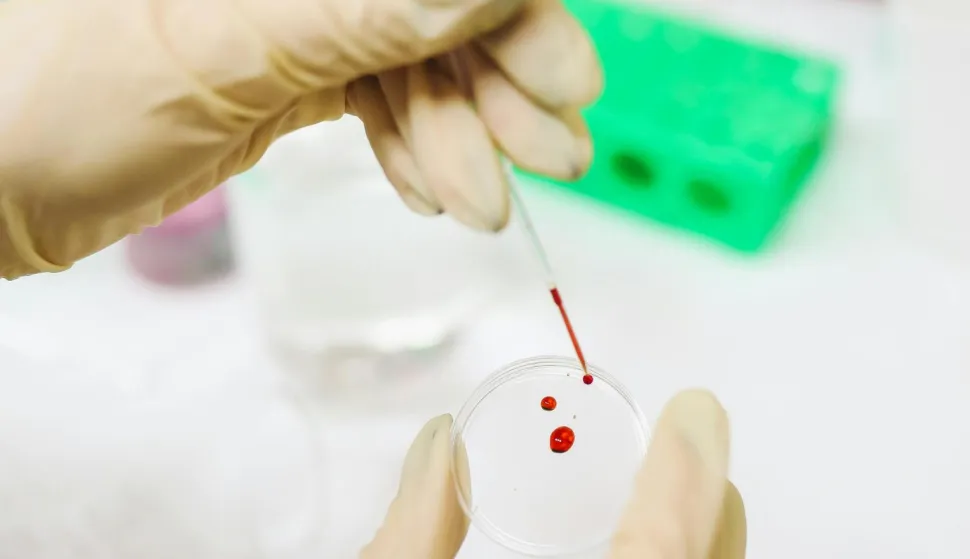
nalaz krvi

Osobe koji imaju visok kolesterol trebaju izbjegavati keto dijetu
Čak i ako njegujete zdrav način života, ali unatoč tomu vaš kolesterol ostaje visok, postoje određeni skriveni razlozi koji mogu biti potencijalni krivci za to. Ako ste netko tko vodi relativno zdrav način života, a imate visok kolesterol, moguće je da su za to odgovorni geni, odnosno neka genetska komponenta koja dovodi do povišenog kolesterola.
Kardiolog Raj Khandwalla sugerira da se u tom slučaju može raditi o takozvanoj obiteljskoj hiperkolesterolemiji, što je nasljedno stanje koje dovodi do nakupljanja kolesterola u krvotoku. Za utvrditi to stanje potrebna je dijagnoza liječnika, koji će potom propisati adekvatnu terapiju. Dr. Khandwalla nadalje tvrdi da krivac može biti i neka pomodna dijeta koja vašem organizmu jednostavno ne odgovara.
On sugerira da osobe koji imaju visok kolesterol trebaju izbjegavati keto dijetu, što je način prehrane s visokim udjelom masti i smanjenim udjelom ugljikohidrata, a na glasu je kao popularna dijeta za mršavljenje. Najučinkovitije dijete za snižavanje kolesterola su biljna prehrana ili ona veganska u kojima se smanjuje unos kolesterola hranom, kaže Khandwalla. Ako ipak želite uključiti meso u svoju prehranu, držite se nemasnih proteina, poput piletine, puretine i ribe.
Za zdravlje srca važno je ograničiti unos zasićenih i trans masti, što u praksi znači jesti manje crvenog i prerađenog mesa (poput kobasica), maslaca i punomasnih mliječnih proizvoda. Umjesto toga, birajte hranu s zdravim masnoćama poput biljnih ulja, orašastih plodova, sjemenki i ribe, piše Everyday Health.
Četiri stvari koje možete učiniti za smanjenje kolesterola su: vježbanje, zdrava prehrana, izbjegavanje pušenja i održavanje zdrave težine.


